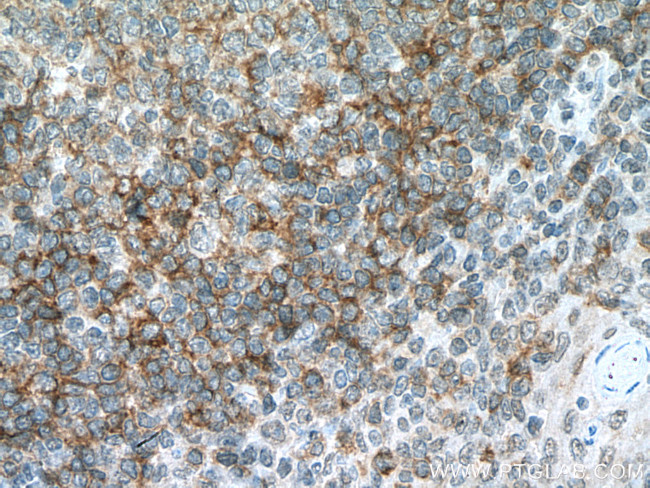
CD72 Antibody in Immunohistochemistry (Paraffin) (IHC (P))

Search
Proteintech
CD72 Monoclonal Antibody (2C1C6)
{{$productOrderCtrl.translations['antibody.pdp.commerceCard.promotion.promotions']}}
{{$productOrderCtrl.translations['antibody.pdp.commerceCard.promotion.viewpromo']}}
{{$productOrderCtrl.translations['antibody.pdp.commerceCard.promotion.promocode']}}: {{promo.promoCode}} {{promo.promoTitle}} {{promo.promoDescription}}. {{$productOrderCtrl.translations['antibody.pdp.commerceCard.promotion.learnmore']}}
产品信息
67424-1-IG
种属反应
宿主/亚型
分类
类型
克隆号
抗原
偶联物
形式
浓度
规格
纯化类型
保存液
内含物
保存条件
运输条件
产品详细信息
Aliquoting is unnecessary for -20°C storage.
靶标信息
CD72 is a transmembrane glycoprotein expressed as a homodimer especially in B cells, but also in other antigen presenting cells such as dendritic cells and macrophages. Through one of its immunoreceptor tyrosine-based inhibitory motives (ITIMs), CD72 interacts with tyrosine phosphatase SHP-1, thereby suppressing B cell responsiveness. Binding of CD72 with its ligand CD100 (Sema4D) prevents BCR association and phosphorylation of CD72 and results in dissociation of SHP-1 from CD72, thus enables B cell activation.
仅用于科研。不用于诊断过程。未经明确授权不得转售。
篇参考文献 (0)
生物信息学
蛋白别名: B-cell differentiation antigen CD72; CD72; CD72 antigen; Lyb-2; one of the receptors for CD100; RP11-331F9.9
基因别名: CD72; CD72b; LYB2
UniProt ID: (Human) P21854
Entrez Gene ID: (Human) 971